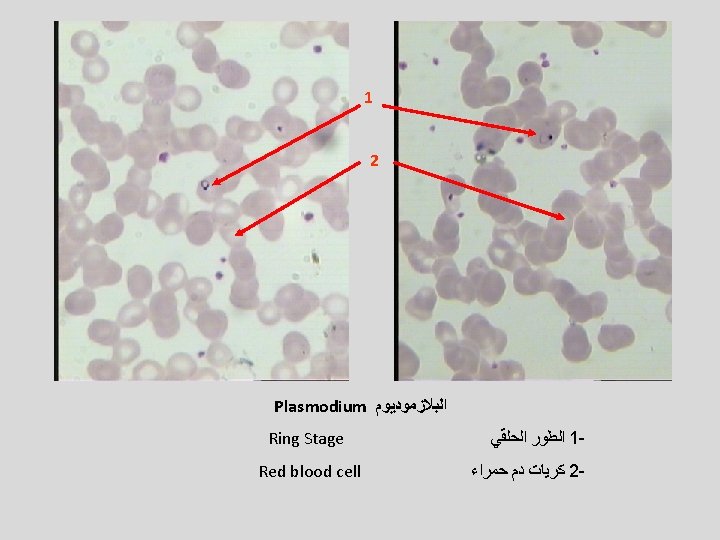
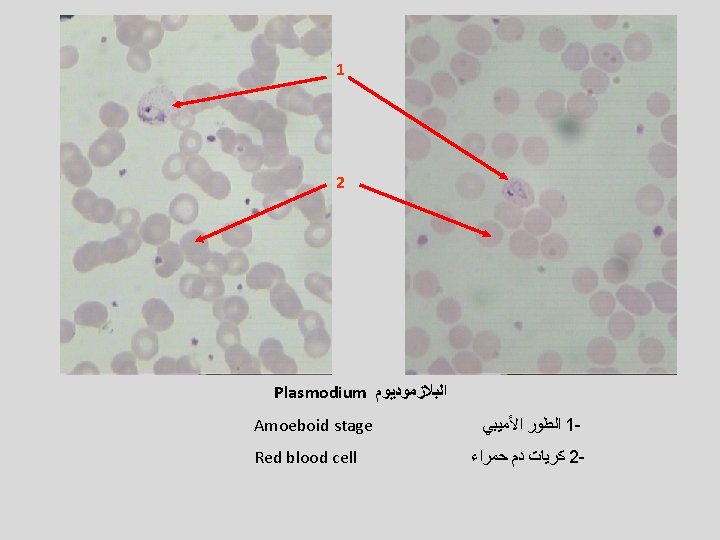
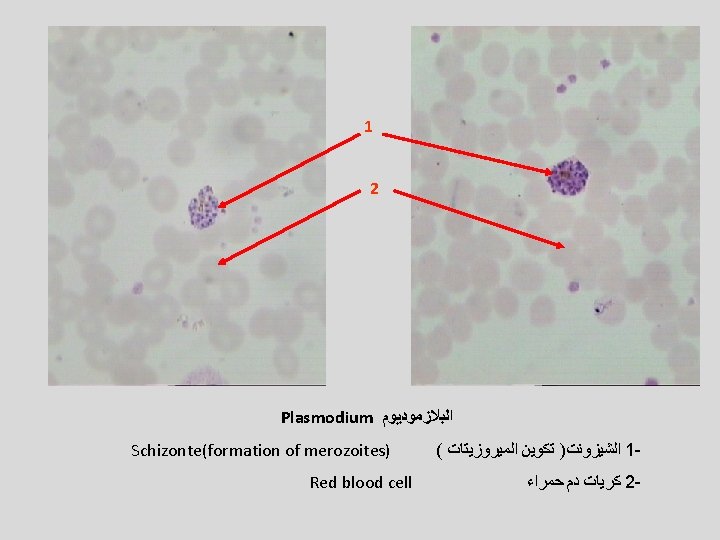
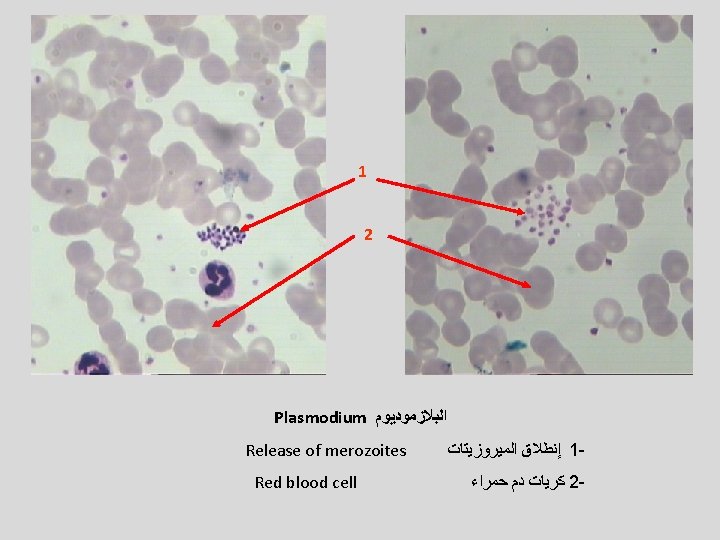

PARASITOLOGY General characteristics v The Protozoa are the

- Slides: 28
PARASITOLOGY
General characteristics v. The Protozoa are the simplest and most primitive animals. v They live either singly or in colonies. Some are parasitic. v. They are usually defined as "unicellular" animals.
Amoeba • Habitat: freshwater ponds. • Means of locomotion: pseudopodia. • Reproduction mechanism: asexually by binary fission, and under unfavourable conditions it encysts. • Shape and characteristics: quite irregular in shape; the body changes its shape constantly with the formation and withdrawal of the pseudopodia. Kingdom : Protista Phylum: Sarcomastigophora Subphylum: Sarcodina Genus : Amoeba Species : Amoeba
nucleus Contractile vacuole Food vacuoles Ectoplasm pseudopodia Endoplasm
Entamoeba histolytica It causes amoebic dysentery. Life cycle : • The trophozoite: feeding dividing form) It has one pseudopodia). • Cyst: have 4 nuclei (infective stages) • Infective stage: Cyst. • Mode of infection: contamination of food and water with cyst. • Characteristic features: Cyst have 4 nuclei. Trophozoite have RBCs in their vacuoles. Kingdom : Protista Phylum: Sarcomastigophora Subphylum: Sarcodina Genus: Entamoeba Species: Entamoeba histolytica
Entamoeba coli • Endamoeba coli: does not cause any known disease • Habitat: large intestine of human. • Characteristics: mature cysts have 8 nuclei Kingdom : Protista Phylum: Sarcomastigophora Subphylum: Sarcodina Genus: Entamoeba Species: Entamoeba coli
Euglena • Habitat: ponds and Kingdom : Protista Phylum : stagnant water. Sarcomastigophora • Characteristics: Green in Subphylum : Mastigophora colour (have chloroplasts) Class : • Means of locomotion: Phytomastigophora Genus : Euglena flagellum • Reproduction: asexually by longitudinal binary fission and is able to form a cyst.
Flagellum Eyespot Second flagellum Nucleus Chloroplast
Trypanosoma Intermediate host: insect or leech Habitat in intermediate host: alimentary canal Definite host: human. Habitat in definite host: blood of man Causes the disease: sleeping sickness. Means of locomotion: flagellum. Feeding habits: absorbing the nutrient subs tances from the host. Reproduction: reproduce asexually by longitudinal binary fission. Major characteristics: long slender, undulating a whip like flagellum. Kingdom : Protista Phylum: Sarcomastigophora Subphylum: Mastigophora Class: Zoomastigophora Genus: Trypanosoma Species: gambiense
Paramecium Means of locomotion: cilia Habitat: freshwater ponds where decaying organic matter is abundant, feeding on it and on bacteria and other micro organisms. Reproduction: asexually by transverse binary fission, and sexually by conjugation. Kingdom : Protista Phylum: Ciliophora Genus: Paramecium
Characteristics: the numerous cilia covering the whole surface of the body. They have two contractile vacuoles and two nuclei: a large oval macro nucleus (for vegetative functions), and a small micronucleus (for reproduction).
Plasmodium malariae Trophozoite: Habitat: live intracellu larly in the blood corpuscles of its vertebrate host. Causes the disease: malaria fever to man. Vector: a mosquito belonging to the genus Anopheles. Kingdom: Protista Phylum: Apicomplexa Class: Sporozoa Genus: plasmodium Species: Plasmodium malaria
Life cycle Asexual stage human Sexual stage mosquito
6. Macrogametocyte 5. Release of merozoites sexual blood stages 4. Formation of Merozoites 6. Microgametocyte sexual blood stages 3. Schizont 1. Ring stage 2. Trophozoite stage feeding and growing stages in red cells Immature trophozoite
Under The microscope
1 3 2 (Euglena) ﺍﻟﻴﻮﺟﻠﻴﻨﺎ Flagellum Contractile vacuole Nucleus ﺍﻟﺴﻮﻁ 1 ﻓﺠﻮﺓ ﻣﺘﻘﺒﻀﺔ 2 ﻧﻮﺍﺓ 3
Thank you for attention